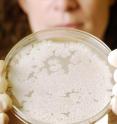
This is assistant professor Wendy Kelly with a culture of the bacterium that produces the antibiotic thiostrepton. This is assistant professor Wendy Kelly with a culture of the bacterium that produces the antibiotic thiostrepton.

Researchers identify genes for thiostrepton, a powerful drug whose use is now limited
Related images
(click to enlarge)
Researchers at the Georgia Institute of Technology have identified the genetic machinery responsible for synthesizing thiostrepton, a powerful antibiotic produced by certain bacteria. Though effective against the dangerous MRSA (methicillin-resistant Staphylococcus aureus) and vancomycin-resistant enterococci, thiostrepton currently has only limited applications in humans because it is not water soluble. Identification of the gene cluster responsible for producing thiostrepton sets the stage for genetic manipulations that could make the drug more useful by improving its water solubility, potentially providing a new tool in the high-stakes battle against bacteria. Beyond the possible medical applications, the research produced a scientific surprise: thiostrepton is derived from a genetically encoded peptide that undergoes no fewer than 19 different modifications, one of the most complex such processes known – and a surprising capability for a single-celled bacterium.
"We are interested in making derivatives of this peptide drug that retain their potency and are efficiently processed by biochemical machinery," said Wendy L. Kelly, an assistant professor in Georgia Tech's School of Chemistry and Biochemistry and the Parker Petit Institute for Bioengineering and Bioscience. "We want to put in substitutions to the genetic machinery that may create a more water soluble analog and could potentially be used for development of a new class of antibacterial agent."
Details of the work were published online in the Journal of the American Chemical Society on March 5. The research was sponsored by the Camille and Henry Dreyfus Foundation, the American Society of Pharmacognosy and Georgia Tech.
Kelly, graduate student Lisa Pan and postdoctoral fellow Chaoxuan Li began their study of thiostrepton by having the genome of one bacterium that produces it -- Streptomyces laurentii – sequenced by a commercial laboratory. They then studied different parts of the genome, searching for the genes responsible for producing the drug.
"It was a combination of DNA sequencing, bioinformatic analysis of the encoded proteins and biochemical characterization," said Kelly. "We didn't really know where on the chromosome this would be localized. Instead of taking a single shot and looking only at one location, we used a shotgun strategy that gave us insight into many different regions on the chromosome at the same time."
Fortunately, in simple organisms like bacteria, genes responsible for a particular task tend to be located close together, so when the researchers found one relevant gene, they knew the rest would be nearby. The researchers produced a knockout mutant to confirm that the genes they had identified were the correct ones.
The mechanism by which the bacterium produces thiostrepton turned out to be of considerable interest. Because peptides produced directly by ribosomal synthesis tend to be comparably simple, researchers had expected the complex thiostrepton molecule to be produced by a non-ribosomal route.
However, the Georgia Tech team showed that the drug results from a process controlled by the ribosome – which makes it a good target for genetic manipulation.
"The fact that we have a gene that produces a peptide that undergoes post-translational modification makes this a simpler target for biosynthetic engineering," Kelly noted. "Before this finding, we didn't know that such extensive modifications could be made to a peptide. Finding this mechanism completely changes how we look at this and similar systems, and changes the potential for biosynthetically engineering effective new systems."
Kelly's research team will next seek to understand the complex pathway used to synthesize the drug, then attempt to modify the right component of that machinery to create a variant of thiostrepton that is water soluble.
"You can think about this in terms of an assembly line for manufacturing cars, with the changes occurring in stages during construction," she said. "The same would be true of a microorganism building up a complex molecule. Some modifications that occur later in the process may require certain key elements to be present first. We need to understand what modifications are necessary and what features of the structure are important for recognition and processing down the line."
Produced by certain terrestrial and marine bacteria, thiostrepton was identified in the 1950s, and first synthesized in the laboratory in 2004. Thiostrepton and related thiopeptide antibiotics fight bacteria by disabling their protein biosynthesis, and also have promising anti-malarial and anti-cancer activity.
Though researchers face many challenges in attempting to modify the genes and enzymes required to produce the drug, the potential benefits are significant.
"With the development of resistance and pathogens such as MRSA, there's a crisis developing in anti-microbial treatments," she noted. "If they were to become resistant to the few drugs that are currently available to fight them, they would become untreatable. There is a big push to identify new drugs for clinical use in humans that are effective against these strains."
With an undergraduate degree in pharmacy and graduate degrees in chemistry, Kelly has focused on natural systems that produce useful drugs.
"I have a profound appreciation for nature's chemistry and how nature makes complex metabolites from very simple building blocks," she said. "If you compare the kinds of transformations that can be done inside a bacterium against what a synthetic chemist can do, you see the power of nature in its ability to catalyze highly specialized reactions under very mild conditions."
Source: Georgia Institute of Technology Research News
Other sources
- Antibiotic thiostrepton genes identifiedfrom UPIThu, 26 Mar 2009, 16:42:07 UTC
- Researchers identify genes for thiostrepton, a powerful drug whose use is now limitedfrom PhysorgMon, 23 Mar 2009, 20:56:08 UTC